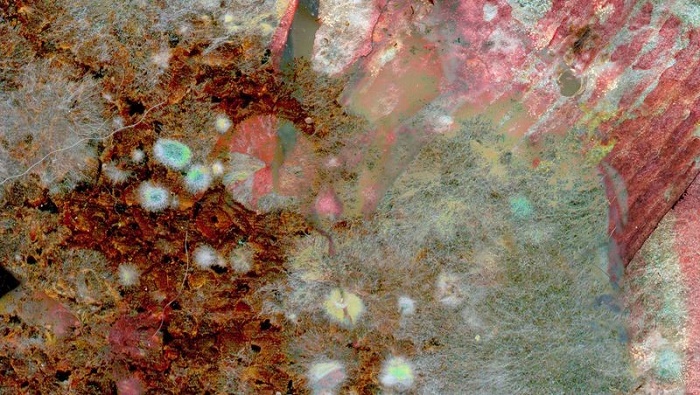

Здравен портал
Учени откриха потенциален източник на нови антибиотици
Учени откриха потенциален източник на нови антибиотици
Снимка:psyberartist / Flickr.com / CC BY 2.0
Шведски и датски учени заявиха, че богат източник на суровини за антибиотици са гъбичките, те разработили метод, който улеснява търсенето на подходящи вещества в природата. За работата си, учените разказват на списание Nature Microbiology.
Търсенето на нови антибиотици е предизвикано от това, че сред бактериите се разпространява устойчивост срещу антибиотиците, в резултат на което, най-простите инфекции могат отново (както е било преди откриването на антибиотиците) да станат смъртоносни.
Авторите на изследването са изолирали геномите на девет различни вида Penicillium - гъбички, от които е бил получен първия антибиотик, пеницилин.
"Открихме, че тези гъбички имат огромен, неизвестен досега потенциал и могат да бъдат използвани за производството на нови антибиотици и други биологично активни съединения, такива като противоракови лекарства", заявява един от авторите, аспирантът на Техническия университет на Чалмерс Дженс Нелсън.
В новите изследвания са представени резултатите от проучването на геномите на 24 гъбички, които учените са търсили гените, отговорни за производството на различни биологично активни съединения. Работата показала, че много гъбички могат да се използват за получаване на нови антибиотици или подобряване на вече известните.
Освен това, авторите се научили да предвиждат кои съединения ще бъдат произведени от организма.
Много проучвания за търсенето на материали за антибиотици са насочени към съединения, произвеждани от бактерии.
"Гъбичките са трудни за изследване, тъй като ние знаем много малко за това, какво те могат да направят, но знаем, че те произвеждат биологично активни вещества в природата за да се предпазят и да оцелеят в борбата за съществуване. Така че е логично да им се обърне внимание", заявява Нелсън.
По-рано, за борба с антибиотичната устойчивост беше създадено специално вещество.
Източник:health.mail.ru











Comments
comments powered by Disqus